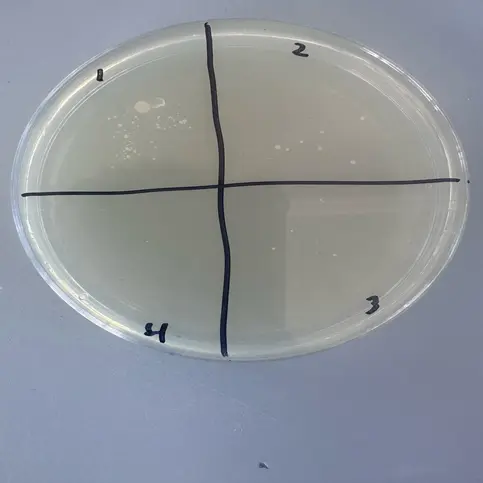
Figure 1: Procedure 1
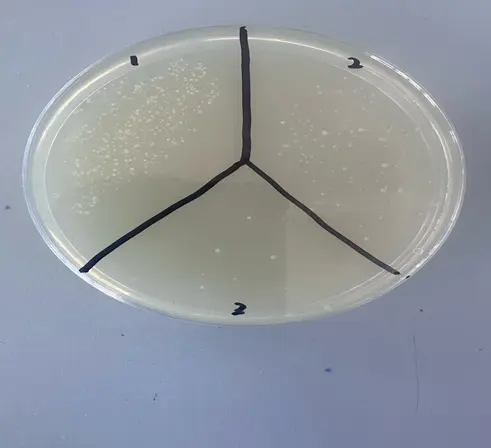
Figure 2: Procedure 2
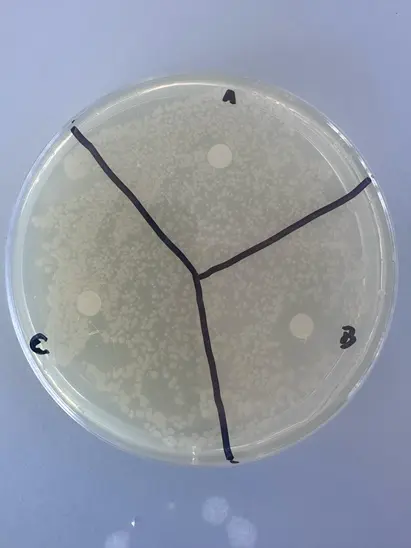
Figure 3: Procedure 3

Hand washing is among the essential activities that help people lower the infection risk because it removes pathogens on the skin's surface. The significance of hand washing was discovered by Ignaz Philipp Semmelweis in 1847 when he found that students carrying material from corpses to maternity patients were a major cause of puerperal fever. He came up with hand washing using chlorinated lime which helped in reducing infection rates significantly. Currently, hand washing is the best-known method of reducing the transmission of healthcare-acquired infections such as methicillin-resistant Staphylococcus aureus, and this foundational concept is often discussed by an assignment helper in UK when explaining infection prevention in clinical education. Proper washing of hands eliminates those bacteria that are on the skin for a short duration thereby reducing the general bacterial count on hands. In addition to washing hands, gloves, sanitizers, and surgical scrubs are some of the significant ways used in the medical field to avoid the transfer of pathogens and enhance the safety of patients and healthcare practitioners.
The rationale of this practical experiment is to ensure that students appreciate the role of washing hands as well as hand sanitization to prevent the spread of microorganisms. It will assist the students in explaining how bacteria are passed from one person to the other by touch and how they can be prevented by washing with soap and using hand sanitizers. Besides, the experiment will involve the use of UV-reactive lotion to illustrate microbial transmission and record the inhibition techniques of antiseptics on Staphylococcus epidermidis through inhibition zones. All in all, this experiment affirms the need for hygiene in the prevention of infections.
Reference materials and sample papers are provided to help students understand assignment structure and improve academic skills. We, as an assignment helper in UK offer guidance while maintaining original work. The Hand Hygiene and Microbial Transfer Handwashing Practical sample highlights report structure, observations, and discussion of findings. These resources are intended solely for study and reference purposes.
A series of experiments were conducted in the Hand Hygiene and Microbial Transfer Handwashing Practical to observe the effect of handwashing, glove use, and sanitizers on microbial transfer. Nutrient and Mueller-Hinton agar plates were used to culture Staphylococcus epidermidis from hands under different conditions. Gloves, handwashing, or sanitizers were applied before contacting the agar to compare bacterial growth. UV-reactive lotion was also used to simulate microbial transfer during handshakes, allowing visualization of contamination spread.
The nutrient agar plate should be divided into four sections namely; before the first glove, Temporary or the transfer zone, and sanitizing zone. It needs to be properly labeled with the date of the experiment and its name. Person 1 flicks his bare finger on the ‘before’ button. Person 1 wears gloves and with the help of the gloved finger taps on the marked label on the scale and denotes it as “Glove 1”. Their gloves are immersed and wiped in the suspending medium of Staphylococcus epidermidis (Ezezika et al. 2023). Person 2, who had protective gloves on, invited person one and began the next trick, performing a handshake and pressing the finger on ‘‘transient’. When their glove is disinfected and rinsed, Person 2 places their finger on “sanitize.” Then it needs to be incubated at the temperature of 37C for 1-2 days.
Get assistance from our PROFESSIONAL ASSIGNMENT WRITERS to receive 100% assured AI-free and high-quality documents on time, ensuring an A+ grade in all subjects.
For spread plate 1, butter, margarine, and oil that is spread on it should be portioned into three equal parts. Unwashed hands are swabbed on 1 section. Hand washing and or swab on section 2. Occasionally, clean the section with sanitizer swab it, and then inoculate section 3. It is incubated at the temperature of 37C for 2 days. Mueller Hinton plate with Staphylococcus epidermidis should be used for spread plate 2. Twelve sterile discs should be placed on the plate with varying equal distances between each one and filled with three various antiseptics. Then it needs to be incubated at the temperature of 37C for 2 days.
Here in this experiment, 4 students have participated. Applying the UV-reactive lotion to the hand gloves of Infected 1. The initial contact is demonstrated through a handshake between Infected 1 and Infected 2, and then through shaking hands with Infected 3 and then with Infected 4. Using UV goggles and light, score the transfer of “infection” from+++ (Infected 1) downwards by the acquires at the relative time intervals To record the relative time intervals for transferring infection from patient-infected 1 to all the others dubbed as; acquires refer to the given points.
After incubation the yeast sample was divided into four quadrants and all of them were evident. The ‘’before’’ quadrant exhibited a high density of bacteria colonies implying that the skin flora is highly existent. The quadrant of “glove 1” yielded small amounts of microorganisms, which confirmed the barrier action of the gloves. Again, the ‘transient’ zone showed profuse growth of Staphylococcus epidermidis thereby suggesting successful transfer of transient bacteria through contact. Substantial diminution in the number of colonies in the “sanitise” quadrant which proves how antiseptic wipes eliminate transient bacteria.
Figure 1: Procedure 1
When comparing the bacterial growth on spread plate 1, Section 1, which represented unwashed hand, there were more colonies while Section 2 which represented hand washed with soap had fewer colonies (Berendes et al. 2022). The last section which was 3 (after hand sanitizer) showed the lowest count, thus proving that the hand sanitizer had killed all the bacteria. On spread plate 2, there are well-defined zones of inhibition around the antiseptic discs that were different in size. Thus, the greatest zone of inhibition was detected for antiseptic 1, meaning that it possesses the highest antibacterial efficacy.
During the “before” quadrant, a dense amount of microbial colonies can be observed due to the presence of normal skin flora and contamination by transient microbes. There are very few microbial colonies present in the “glove 1” sector, which shows that gloves help prevent direct contact contamination. In the “transient” quadrant, there are many bacterial colonies, which verify the transfer of Staphylococcus epidermidis from Person 1 to Person 2 due to the hand contact transient bacteria are spread easily.
The microbes present in the ‘sanitize’ quadrant are significantly lower than in the other parts illuminating that disinfectant is capable of eradicating most skin flora from gloves or skin surface.
Figure 2: Procedure 2
Among these plates, some display the bacterial load prior to hand washing and after using antiseptics (Ross et al. 2023). Section 1 (unwashed hands) also shows densely populated bacterial count. Section 2 which was washed with soap presents very low count as compared to other section of the agar plates. It can be seen that after sanitising the bacterial volume in section 3 is low thus giving credence to the effectiveness of sanitiser as being the most effective cleaner. There is a definition of a clear zone of inhibition around the antiseptic discs, though with different sizes (Syed, and A. Al-Rawi, 2024). The biggest zone of inhibition shows that the antiseptic being tested is highly effective against Staphylococcus epidermidis.
Such observation of the wound reveals differences in antiseptic effects between the two groups of animals (Caruso et al. 2025). The size of clear zones reflects the effectiveness of biocides and helps to determine the use of disinfectants in clinical work.
Figure 3: Procedure 3
These can be demonstrated with contamination transfer using UV reactive lotion. There is strong fluorescence (++++) meaning that the sample is fully contaminated. Infected 2 shows a slightly lesser amount of fluorescence (+++), while Infected 3 shows still less amount of fluorescence (++) which indicates a less contaminated level with reference to indirect contact (Enkhbat et al. 2022).
It remains to note that, within each level of contact, the level of contamination is considerably low, but it is still possible to detect residues of bacteria if there is no proper wash with water and soap. When exposed to UV light, Infected 1 was seen to fluoresce most (++++) which implies maximum contamination. In Infected 2 and 3, the brightness was somewhat lower: they had two plus-three and two plus-two respectively and Infected 4 had only one plus. The results depicted in figure 2 illustrated that Infected 1 had a very strong fluorescence (++++) when exposed to UV light, suggesting that the sample had been exposed to the simulated pathogen to the fullest extent (Thorseth et al. 2024). Infected 2 was shown to be slightly weaker (+++) indicating that there was only a partial transfer. Thus, the results of Infected 3 conformed well to those of the control, characterized by moderate contamination (++). Infected 4 also showed very close to zero contamination (+), which makes it clear that it is the least likely to transfer after several contacts.
Conclusion
After incubation the yeast sample was divided into four quadrants and all of them were evident. The ‘’before’’ quadrant exhibited a high density of bacteria colonies implying that the skin flora is highly existent. The quadrant of “glove 1” yielded small amounts of microorganisms, which confirmed the barrier action of the gloves. Again, the ‘transient’ zone showed profuse growth of Staphylococcus epidermidis thereby suggesting successful transfer of transient bacteria through contact. Substantial diminution in the number of colonies in the “sanitize” quadrant proves how antiseptic wipes eliminate transient bacteria. Procedure 3 proved that it only requires physical contact in some form and there is the transfer of contaminant, especially touching on how condemnatory necessary contact ought to be done to avoid the spread of the disease-causing microorganisms.
The results from the Hand Hygiene and Microbial Transfer Handwashing Practical clearly demonstrate that proper handwashing, sanitizer use, and glove application significantly reduce microbial transfer. Sources of error could be; the application of pressure in the inoculation process, adequate drying after the sanitation process, or the application of the antiseptic discs. Further enhancements can include quantitative CFU determinations and varying the contact time with the antiseptics. In conclusion, this specific experiment further supports the idea that the basics such as washing hands and sanitizing decrease the emergence of temporary bacteria, saving patients’ and HCWs’, time by preventing HCAIs (MacLeod et al. 2023). Therefore, it is recommended that healthcare practitioners use WHO Five Moments of Hand Hygiene in the infection prevention approaches.
References
Introduction: Financial Management Assignment Financial management is a very crucial activity within an organisational...View and Download
Introduction to Business Finance Assignment Ratio analysis refers to the study of line items that appear in a company’s...View and Download
Introduction - PE7018 Law and Surveying Professional Practice Assignment Sample This report addresses the legal and surveying...View and Download
Introduction Get free samples written by our Top-Notch subject experts for taking Assignment...View and Download
Introduction: Strategic Planning Get free samples written by our Top-Notch subject experts for taking Assignment Help...View and Download
Introduction to The Importance Of Equality And Diversity In Primary Education Equality is defined as providing fair treatment to...View and Download